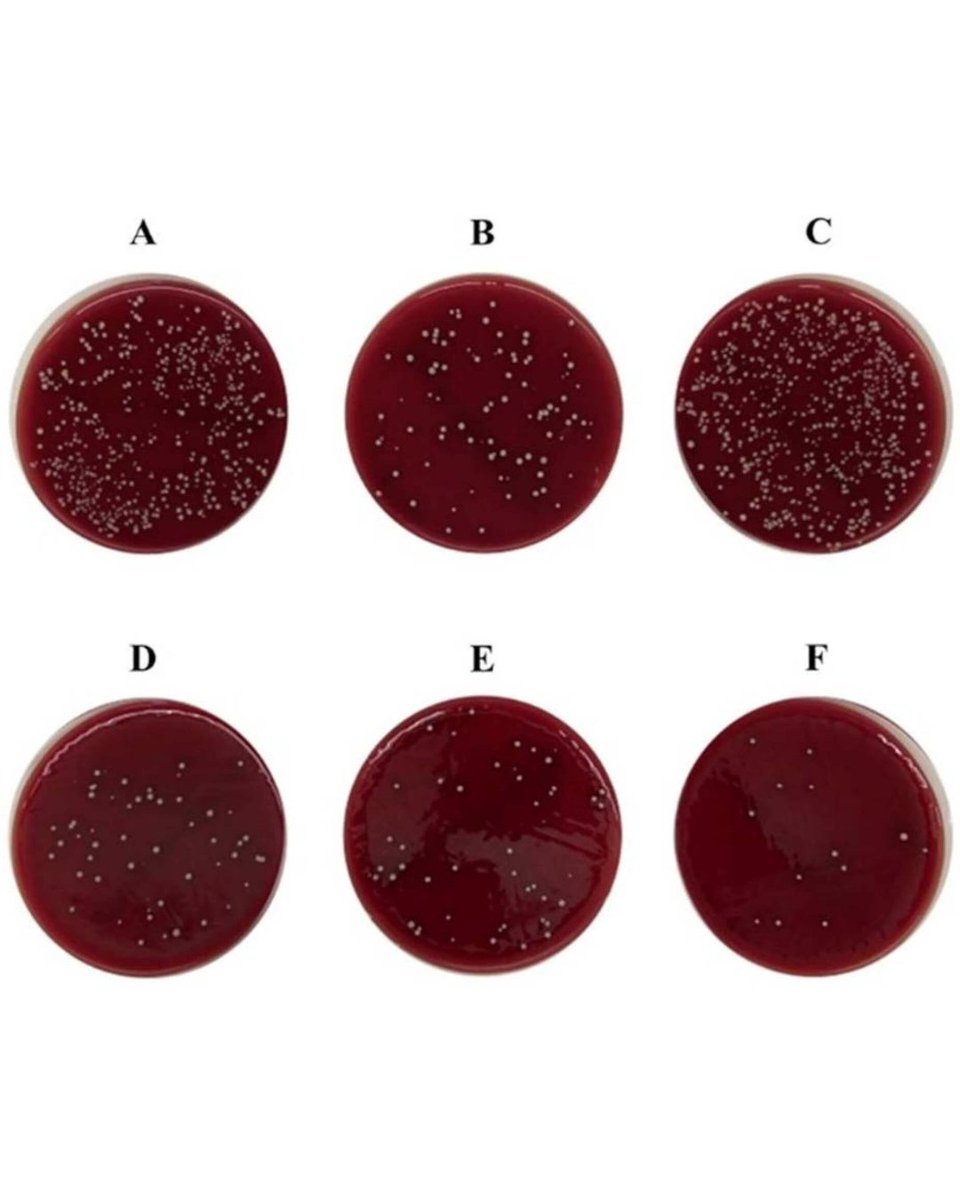
BoneJointRes's tweet image. Povidone-iodine irrigation significantly reduces both positivity rates and bacterial loads of common pathogens, particularly coagulase-negative staphylococci.

#BJR #Shoulder #Arthroplasty #Infection

ow.ly/lxCs50YzGmM

#arthroplasty search results
A new handheld tool was designed to measure the push force intra-operatively, accurately, and safely into position during total knee #arthroplasty surgery. asmedigitalcollection.asme.org/medicaldevices… #medicaldevice #kneereplacement

The study indicates that, for geriatric displaced femoral neck fractures, hemiarthroplasty results in a significantly lower surgical readmission rate within 90 days compared to THA. #BJJ #Healthcare #Arthroplasty #Fracture #Trauma ow.ly/48yF50UpSLX

Tissue sampling is recommended in all revision arthroplasty cases, and specimens should be analyzed by an experienced pathologist. Histopathological analysis can be used as a major criterion in the diagnosis of PJIs. #Infection #PJI #Arthroplasty ow.ly/kOZk50XX8yi

Non-responders of routinely collected PROM scores in hip and knee arthroplasty had significantly increased mortality and significantly worse baseline scores despite similar demographics and revision risk. #PROMs #Arthroplasty #Surgery ow.ly/5Jm350XVXX5

The TARIC total ankle arthroplasty (TAA) implant improved patient-reported clinical outcomes similarly to the outcomes reported in previous studies with other modern TAA implants. #AnkleArthroplasty #Arthroplasty #BJJ ow.ly/vYSs50XW1BS

In the latest #OrthoJOE, Mo and Marc are joined by guest Daniel Berry, MD in a discussion on the promise, current challenges, and future of #robotics in #arthroplasty. Listen to the full episode wherever you get your podcasts or with the link below. tinyurl.com/4yd8acdz
Polymicrobial PJI remains a difficult condition to treat, with high morbidity requiring a tailored multidisciplinary approach. The poor long-term functional outcomes highlight the need for optimization of treatment protocols. #Infection #Arthroplasty ow.ly/VE8Y50XJGQn

Achieving quadriceps strength within the distribution of older adults without knee OA following TKA is associated with clinically meaningful differences in satisfaction and functional activities. #Osteoarthritis #Arthroplasty #Knee #Quadriceps #Muscle ow.ly/9CHK50YEZ7I

Adequate weight-adjusted cephalosporin dosing reduces the risk of surgical site infection after total hip arthroplasty and total knee arthroplasty. #BJO #Arthroplasty #Infection #Surgery @helen_badge @timchurches @doctordoubter ow.ly/tjje50YtpWi

While both their surgical and medical management have advanced tremendously in recent decades, several aspects of the use of arthroplasty in patients with a hip fracture remain controversial. #Arthroplasty #HipFracture #BJJ @bjjeditor ow.ly/rQct50Y9aA0

Robotic-assisted total knee arthroplasty resulted in greater improvement and a higher likelihood of achieving expectation fulfilment of daytime pain relief when compared to manual surgery. #RoboticAssistedSurgery #TKA #Arthroplasty #Knee #BJJ ow.ly/jwn150Yo5sz

Povidone-iodine irrigation significantly reduces both positivity rates and bacterial loads of common pathogens, particularly coagulase-negative staphylococci. #BJR #Shoulder #Arthroplasty #Infection ow.ly/lxCs50YzGmM
Specialising in knee surgery, Mr Sam Oussedik is one of the authors of a new study assessing the implant survival and patient-reported outcome measures of robotic arm-assisted patellofemoral arthroplasty. Read it now! #Arthroplasty #Knee #Robotics ow.ly/1PzE50Yi2F7

Robotic arm-assisted patellofemoral arthroplasty was associated with clinically meaningful postoperative outcome measures and a high net promoter score; however, approximately one in five were not satisfied. #Arthroplasty #RoboticArm #Ortho #Knee ow.ly/SfH450Y9Qym

This study uses prospective registry data to compare early patient outcomes following arthroscopic repair or debridement of the acetabular labrum. #Healthcare #Arthroplasty #BJO @DrHolleyman @orthoepi @mbankes @tim_n_board @cwmcbryde @CambridgeHipDoc ow.ly/cv4650Ypg10

"Dr. Narinder Kumar, MBBS, MSurg(Ortho) discusses the recent #JBJS article titled Demographics, Indications, and Revision Rates for Radial Head Arthroplasty" Read the article bit.ly/41NINjy #arthroplasty #JBJS
Compared to TKA, faster walking speeds, nearer-normal vertical ground reaction forces, longer stride lengths, and a more consistent gait pattern demonstrate the importance of functional cruciate ligaments to gait. #Arthroplasty #Patients #Research #BJR ow.ly/IJeo50Yan8c

Distal femur morphology varies systematically across sex and ethnicity, highlighting the importance of accounting for patient-specific morphology in the treatment of orthopaedic conditions. #KneeSurgery #Arthroplasty #OpenAccess #Patients #BJO ow.ly/kvvG50YB9fz

The BioFire Joint Infection panel helped to resolve cases with unclear microbiological results related to unexpected-negative cultures, unexpected-positive cultures, and single-intraoperative positive cultures. #BJR #Infection #Arthroplasty #Research ow.ly/2Bxz50XU79N

#kneeimplant #TKR #arthroplasty #FEA #orthopedics #biomechanics #CAD #ANSYS #SolidWorks #kneeOA #jointreplacement #biomaterials #UHMWPE #3Dprinting #medtech #biomedicalengineering #finiteelementanalysis #posteriorstabilized #jointdesign #rRuskin #Anglia #Dissertation #Mechanical

Overall, 14.5% of TAA patients went on to have further procedures to the hindfoot joints, while 24.2% of arthrodesis patients had further procedures. #Arthrodesis #Arthroplasty #Ankle #Surgery #Ortho @NewcastleHosps boneandjoint.org.uk/Article/10.130…

Does surgical approach affect THA dislocation mechanics? 🧐 DAA dislocations show 41.3% adverse spinopelvic mobility vs 21.1% in PA. Hip-spine assessment matters! 🦴 #OrthoTwitter #Arthroplasty link.springer.com/article/10.118…
Precision, durability and functional success in modern knee arthroplasty. Otimed knee prosthesis solutions support mobility through advanced orthopedic technologies. #KneeImplant #Arthroplasty #Orthopedics #Otimed #MedTech

Join us in Newcastle this June for the Ankle Arthritis Academy 2026 (9–10 June) for 2 days of expert lectures, case discussions & workshops covering #anklearthritis, fusions & #arthroplasty. Early bird rates apply until 1 May. Register now: clockworkmedical.com/meeting/ankle-… #MedEd

This study supports the continued provision of total shoulder arthroplasty procedures performed in rural hospitals by experienced surgeons. #BJO #Shoulder #Arthroplasty #Healthcare #Surgeons ow.ly/E2yo50YB9A3

Our featured author this month is Prof Martin Lindberg-Larsen, an author on a paper published this month. The article investigates patient safety after day-case and non-day-case hip and knee #arthroplasty in a public healthcare setting. #DayCase #Surgery ow.ly/SulH50YMBZ2

Does adding TXA to LIA cocktails improve TKA recovery? A new RCT shows reduced early pain & swelling, plus less Hb drop (26.2 vs 33.5 g/L)! 🩸🦵 #OrthoTwitter #Arthroplasty link.springer.com/article/10.118…
Reverse and anatomic total shoulder #arthroplasty had comparable return to sport and satisfaction rates in patients aged 65 years and younger. #AAOS2026 @aaos1 Read more: vist.ly/4z49d
Today we're talking about a different kind of joint... 4:20 Throwback: Self-Reported Cannabis Use Is Associated With a Lower Rate of Persistent Opioid Use After Total Joint Arthroplasty 📓: arthroplastytoday.org/article/S2352-… #420 #OrthoTwitter #Arthroplasty #Opioids #PainManagement




🦴 LATERAL UNICOMPARTMENTAL KNEE ARTHROPLASTY IS ASSOCIATED WITH NEARER-NORMAL GAIT CHARACTERISTICS AND HIGHER PATIENT SATISFACTION COMPARED TO TOTAL KNEE ARTHROPLASTY 🦵 Read the full paper below! #KneeSurgery #Arthroplasty #OrthoTwitter #BJR boneandjoint.org.uk/Article/10.130…
Migration patterns of uncemented femoral stems in hip replacement: a systematic review and meta-analysis of clinical radiostereometric analysis cohort studies Lisa van der Water et al. doi.org/10.2340/174536… #Arthroplasty #Femoral #Hip #Implants #Osteoarthrosis

Fast-track primary hip and knee arthroplasty can be safely implemented in a multicentre public healthcare system with unselected patients. #Healthcare #Arthroplasty #Hip #Knee #DayCase ow.ly/nIlp50YGqOv

Why do hips dislocate after revision THA? 🧐 Functional combined anteversion (FCA) is significantly higher in dislocated cases (50.0° vs 35.6°). 🦴 #OrthoTwitter #Arthroplasty link.springer.com/article/10.118…
Distal femur morphology varies systematically across sex and ethnicity, highlighting the importance of accounting for patient-specific morphology in the treatment of orthopaedic conditions. #KneeSurgery #Arthroplasty #OpenAccess #Patients #BJO ow.ly/kvvG50YB9fz

The Actis collared cementless femoral stem demonstrates excellent functional outcomes at short-term follow-up, with low rates of periprosthetic fracture and revision surgery. #Arthroplasty #Fracture #Patient #Surgery #BJO ow.ly/XyIm50YAMEs

The latest arthroplasty research, including studies on preoperative methadone, 1.5-stage and two-stage revisions for periprosthetic joint infection, and total joint replacement, summarized in #BJ360! #Arthroplasty #OrthoTwitter #Surgery #ClinicalTrials boneandjoint.org.uk/Article/10.130…

Are age or BMI true contraindications for UKA? 🧐 New 5-year data shows 96% satisfaction regardless of patient demographics! 📈 #OrthoTwitter #Arthroplasty link.springer.com/article/10.118…
@AAOS1 #AJRR is now accepting applications for the 2026–2027 Research Fellowship. If you are an #orthopaedic surgery resident, #arthroplasty fellow or orthopaedic surgeon within 5-years of practice should apply. Deadline to apply is May 15 login.auth.aaos.org/signon?environ…
Research Trends on Perioperative Complications of Knee Replacement: A Bibliometric Analysis 🌷doi.org/10.4055/cios25… Clin Orthop Surg. 2026;18(2). Wei Liang #KneeReplacement #IntraoperativeComplications #Arthroplasty #Bibliometrics #CiteSpace

There may be perhaps no better case study for the need for cyber-physical systems of the #IndustrialRevolution 4.0 to improve the treatment for #arthrodesis, #arthroplasty, and #arthroscopy. bit.ly/3IyetNp

A new handheld tool was designed to measure the push force intra-operatively, accurately, and safely into position during total knee #arthroplasty surgery. asmedigitalcollection.asme.org/medicaldevices… #medicaldevice #kneereplacement

Distal femur morphology varies systematically across sex and ethnicity, highlighting the importance of accounting for patient-specific morphology in the treatment of orthopaedic conditions. #KneeSurgery #Arthroplasty #OpenAccess #Patients #BJO ow.ly/kvvG50YB9fz

Adequate weight-adjusted cephalosporin dosing reduces the risk of surgical site infection after total hip arthroplasty and total knee arthroplasty. #BJO #Arthroplasty #Infection #Surgery @helen_badge @timchurches @doctordoubter ow.ly/tjje50YtpWi

The study indicates that, for geriatric displaced femoral neck fractures, hemiarthroplasty results in a significantly lower surgical readmission rate within 90 days compared to THA. #BJJ #Healthcare #Arthroplasty #Fracture #Trauma ow.ly/48yF50UpSLX

#NEUVisualAbstract Incidence and Risk Factor of Implant Dislocation After #Cervical Disk #Arthroplasty: A Retrospective Cohort Analysis of 756 Patients by Ko et al Taipei Veterans General Hospital @JohnHShinMD @CNS_Update @Zaazoue @urquiagajf_MD @DKondziolkaCNS

Polymicrobial PJI remains a difficult condition to treat, with high morbidity requiring a tailored multidisciplinary approach. The poor long-term functional outcomes highlight the need for optimization of treatment protocols. #Infection #Arthroplasty ow.ly/VE8Y50XJGQn

Is adding a second compartment instead of converting straight to total knee arthroplasty after failed UKA a good idea? #knee #arthroplasty #revision #outcomes #clinicalstudies #KSSTA Read here: doi.org/10.1002/ksa.70…

Biomechanical testing can help us to better understand how implant design influences knee kinematics. This study presents a novel way of doing so. #knee #arthroplasty #biomechanics #openaccess #KSSTA Read here: doi.org/10.1002/ksa.12…

Tissue sampling is recommended in all revision arthroplasty cases, and specimens should be analyzed by an experienced pathologist. Histopathological analysis can be used as a major criterion in the diagnosis of PJIs. #Infection #PJI #Arthroplasty ow.ly/kOZk50XX8yi

Achieving quadriceps strength within the distribution of older adults without knee OA following TKA is associated with clinically meaningful differences in satisfaction and functional activities. #Osteoarthritis #Arthroplasty #Knee #Quadriceps #Muscle ow.ly/9CHK50YEZ7I

A CT-based simulation study comparing KA and MA in TKA found that KA produced greater medial but smaller lateral PFCO when a medial-pivot implant designed for mechanical alignment was used. #knee #arthroplasty #kinematicalignment #KSSTA Read here: doi.org/10.1002/ksa.70…

Non-responders of routinely collected PROM scores in hip and knee arthroplasty had significantly increased mortality and significantly worse baseline scores despite similar demographics and revision risk. #PROMs #Arthroplasty #Surgery ow.ly/5Jm350XVXX5

The TARIC total ankle arthroplasty (TAA) implant improved patient-reported clinical outcomes similarly to the outcomes reported in previous studies with other modern TAA implants. #AnkleArthroplasty #Arthroplasty #BJJ ow.ly/vYSs50XW1BS

This study uses prospective registry data to compare early patient outcomes following arthroscopic repair or debridement of the acetabular labrum. #Healthcare #Arthroplasty #BJO @DrHolleyman @orthoepi @mbankes @tim_n_board @cwmcbryde @CambridgeHipDoc ow.ly/cv4650Ypg10

Specialising in knee surgery, Mr Sam Oussedik is one of the authors of a new study assessing the implant survival and patient-reported outcome measures of robotic arm-assisted patellofemoral arthroplasty. Read it now! #Arthroplasty #Knee #Robotics ow.ly/1PzE50Yi2F7

This new KSSTA paper introduces a novel method of setting the posterior tibial slope in kinematically aligned TKA. #knee #TKA #arthroplasty #slope #KSSTA Read here: doi.org/10.1002/ksa.12…

Meet Dr. Carl L. Herndon, Hip & Knee Reconstruction surgeon & Assistant Professor at #ColumbiaOrthopedics! He's dedicated to patient care, clinical excellence, & research. Off-duty, he enjoys NYC's outdoors & culture. Fun fact: He's been on 12 medical missions! #Arthroplasty




🚨 New episode available! 🚨 In today’s discussion, we examine @BoneJointOpen research on the effect of lipped liners on implant survival in primary total hip arthroplasty. Full breakdown below! #AITalks #Podcast #Arthroplasty #OrthoTwitter #Research ow.ly/1N3550Ys1XT

Robotic-assisted total knee arthroplasty resulted in greater improvement and a higher likelihood of achieving expectation fulfilment of daytime pain relief when compared to manual surgery. #RoboticAssistedSurgery #TKA #Arthroplasty #Knee #BJJ ow.ly/jwn150Yo5sz

Something went wrong.
Something went wrong.
United States Trends
- 1. Lemon N/A
- 2. McVay N/A
- 3. #Kehlani N/A
- 4. Rams N/A
- 5. Stafford N/A
- 6. Ty Simpson N/A
- 7. Jokic N/A
- 8. Jaden McDaniels N/A
- 9. bain N/A
- 10. Steelers N/A
- 11. #SECAwards N/A
- 12. Jets N/A
- 13. Caleb Downs N/A
- 14. Wack N/A
- 15. #zzzSpecialProgram N/A
- 16. Enid N/A
- 17. DeepSeek V4 N/A
- 18. Nuggets N/A
- 19. Eagles N/A
- 20. Beane N/A


























